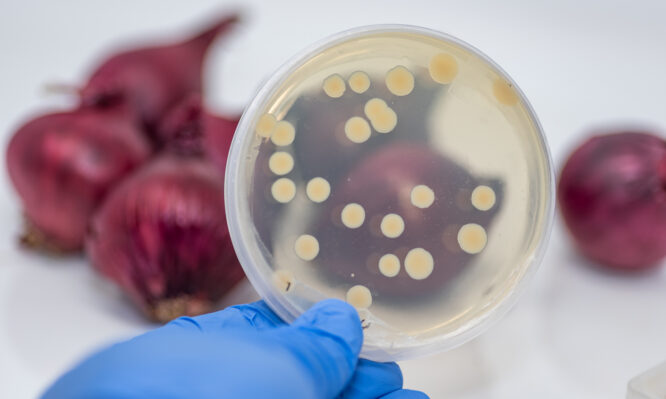
e.coli, κρεμμύδια

Αυξάνεται ο αριθμός των ατόμων που μολύνθηκαν από το βακτήριο E.coli μετά από γεύμα σε πασίγνωστη αλυσίδα
Συνεχίζει να αυξάνεται ο αριθμός των ανθρώπων στις ΗΠΑ που μολύνθηκαν από το βακτήριο E.coli (Εσερίχια κόλι) μετά την κατανάλωση φαγητού στην αλυσίδα McDonald’s και πλέον φτάνει τους 75, ανακοίνωσαν χθες, Παρασκευή 25/10, οι αμερικανικές υγειονομικές αρχές.
Τουλάχιστον 22 άνθρωποι νοσηλεύονται και λοιμώξεις έχουν πλέον καταγραφεί σε 13 πολιτείες, επεσήμανε η Αμερικανική Υπηρεσία Φαρμάκων (FDA). Δύο άνθρωποι έχουν παρουσιάσει αιμολυτικό- ουραιμικό σύνδρομο, που ενδέχεται να προκαλέσει σοβαρή νεφρική ανεπάρκεια.
Ένας άνθρωπος έχει χάσει τη ζωή του.
Από τους 42 ασθενείς που ερωτήθηκαν, όλοι απάντησαν ότι έφαγαν στα McDonald’s και 39 δήλωσαν ότι κατανάλωσαν ένα συγκεκριμένο χάμπουργκερ.
Η FDA «χρησιμοποιεί όλα τα διαθέσιμα εργαλεία για να επιβεβαιώσει αν τα κρεμμύδια είναι η αιτία της επιδημίας», επεσήμανε η υπηρεσία σε ανακοίνωσή της.
Η έρευνα συνεχίζεται αλλά «η “Taylor Farms”, η εταιρεία που παρέχει στα McDonald’s κομμένα κρεμμύδια, ανακοίνωσε εθελοντικά την ανάκλησή τους», διευκρίνισε η FDA.
Η εταιρεία έχει επίσης ενημερώσει τους υπόλοιπους πελάτες της.
Τα McDonald’s ανακοίνωσαν την Τρίτη ότι αποσύρουν τα κρεμμύδια από τα εστιατόριά τους στις πολιτείες όπου έχουν καταγραφεί κρούσματα μόλυνσης από το E.coli. Παράλληλα η εταιρεία έχει αποσύρει «για προληπτικούς λόγους» το συγκεκριμένο χάμπουργκερ που περιέχει αυτά τα κρεμμύδια, το Quarter Pounder.
Χθες Παρασκευή η εταιρεία διευκρίνισε ότι η Taylor Farms, πριν το περιστατικό αυτό, προμήθευε κρεμμύδια σε περίπου 900 εστιατόρια McDonald’s. Η αλυσίδα ταχυφαγείων επεσήμανε εξάλλου ότι «έλαβε την απόφαση να σταματήσει επ’ αόριστον να προμηθεύεται κρεμμύδια από την Taylor Farms».
Κανένα κρούσμα μόλυνσης από το E.coli δεν έχει αναφερθεί στην FDA εκτός ΗΠΑ.
Τουλάχιστον δύο προσφυγές έχουν ήδη κατατεθεί εξ ονόματος των ασθενών, δήλωσε στο AFP ο Ρον Σάιμον δικηγόρος των εναγόντων. Κάθε ένας ζητεί αποζημίωση ύψους τουλάχιστον 50.000 δολαρίων.
Ένας από τους ασθενείς, ο Έρικ Στίλι κάτοικος Κολοράντο, πήγε στα McDonald’s στις 4 Οκτωβρίου και άρχισε να εμφανίζει γαστρεντερικά συμπτώματα δύο ημέρες αργότερα, περιγράφεται σε ανακοίνωση. Ο Στίλι χρειάστηκε να πάει στο τμήμα επειγόντων νοσοκομείου για να λάβει φροντίδα.
«Η επιδημία E.coli στα McDonald’s θα είναι μια από τις σοβαρότερες επιδημίες τροφικής δηλητηρίασης φέτος», σχολίασε ο Σάιμον, ο οποίος εκπροσωπεί συνολικά 25 ασθενείς. «Χάρη σε αυτή την προσφυγή στη δικαιοσύνη όπως και σε άλλες θα φροντίσουμε όλα τα θύματα να αποζημιωθούν», πρόσθεσε.
Το βακτήριο E.coli προκαλεί πόνους στο στομάχι, διάρροια και εμετούς, που γενικά διαρκούς τρεις με τέσσερις ημέρες. Οι περισσότεροι ασθενείς ξεπερνούν τη μόλυνση χωρίς να λάβουν θεραπεία, αλλά κάποιοι ενδέχεται να εμφανίσουν επιπλοκές.
Πηγή: ΑΠΕ-ΜΠΕ
Φωτογραφία: iStock
ΔΙΑΒΑΣΤΕ ΕΠΙΣΗΣ:
E.coli, λιστέρια, σαλμονέλα: Γιατί αυξάνονται κρούσματα και ανακλήσεις τροφίμων σε όλο τον κόσμο
Δίαιτα: 5 κακές συνήθειες που πρέπει να «κόψετε» όταν θέλετε να χάσετε κιλά







